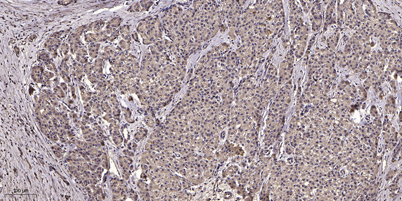

$148.00/50µL $248.00/100µL
| 50 µL | $148.00 |
| 100 µL | $248.00 |
| Product name: | NFAT5 (phospho Ser155) rabbit pAb |
| Reactivity: | Human;Mouse |
| Alternative Names: | NFAT5; KIAA0827; TONEBP; Nuclear factor of activated T-cells 5; NF-AT5; T-cell transcription factor NFAT5; Tonicity-responsive enhancer-binding protein; TonE-binding protein; TonEBP |
| Source: | Rabbit |
| Dilutions: | WB 1:500-2000;IHC-p 1:50-300 |
| Immunogen: | The antiserum was produced against synthesized peptide derived from human NFAT5/TonEBP around the phosphorylation site of Ser155. AA range:121-170 |
| Storage: | -20°C/1 year |
| Clonality: | Polyclonal |
| Isotype: | IgG |
| Concentration: | 1 mg/ml |
| Observed Band: | 200kD |
| GeneID: | 10725 |
| Human Swiss-Prot No: | O94916 |
| Cellular localization: | Nucleus . Cytoplasm . Nuclear distribution increases under hypertonic conditions. . |
| Background: | The product of this gene is a member of the nuclear factors of activated T cells family of transcription factors. Proteins belonging to this family play a central role in inducible gene transcription during the immune response. This protein regulates gene expression induced by osmotic stress in mammalian cells. Unlike monomeric members of this protein family, this protein exists as a homodimer and forms stable dimers with DNA elements. Multiple transcript variants encoding different isoforms have been found for this gene. [provided by RefSeq, Jul 2008], |